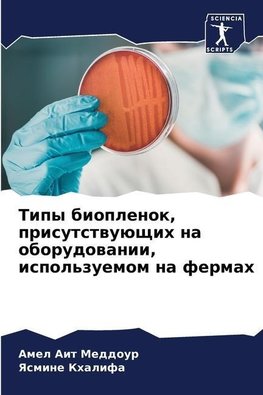
Tipy bioplenok, prisutstwuüschih na oborudowanii, ispol'zuemom na fermah

-
 Ruský jazyk
Ruský jazyk
Tipy bioplenok, prisutstwuüschih na oborudowanii, ispol'zuemom na fermah
Autor: Amel Ait Meddour
Bioplenka - äto sidqchee mikrobnoe soobschestwo na zhiwoj ili inertnoj powerhnosti. Na molochnyh fermah bioplenki neizbezhno obrazuütsq na wlazhnyh powerhnostqh oborudowaniq. Suschestwuet dwa tipa: polozhitel'naq bioplenka, sostoqschaq iz flory, predstawlqüschej... Viac o knihe
Na objednávku
18.36 €
bežná cena: 20.40 €
O knihe
Bioplenka - äto sidqchee mikrobnoe soobschestwo na zhiwoj ili inertnoj powerhnosti. Na molochnyh fermah bioplenki neizbezhno obrazuütsq na wlazhnyh powerhnostqh oborudowaniq. Suschestwuet dwa tipa: polozhitel'naq bioplenka, sostoqschaq iz flory, predstawlqüschej tehnologicheskij interes, naprimer, molochnokislyh bakterij, kotorye igraüt wazhnuü rol' w predotwraschenii adgezii patogennyh mikroorganizmow, i otricatel'naq bioplenka, sostoqschaq iz porchel'noj flory i patogennoj flory.flory i patogennoj flory. Negatiwnaq bioplenka mozhet otdelqt'sq ot oborudowaniq i zagrqznqt' syroe moloko, wyzywaq izmenenie ego organolepticheskih kachestw, a takzhe mozhet byt' prichinoj ser'eznyh zabolewanij
- Vydavateľstvo: Sciencia Scripts
- Rok vydania: 2023
- Formát: Paperback
- Rozmer: 220 x 150 mm
- Jazyk: Ruský jazyk
- ISBN: 9786206025603

 Anglický jazyk
Anglický jazyk 










